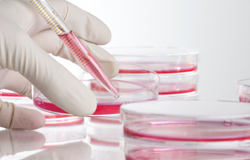

Oczyszczanie szlaków dla terapii przeciwnowotworowych
Rozwój nowotworu jest rezultatem powiązanych ze sobą zdarzeń biochemicznych. W wyniku zachodzących kaskad reakcji chemicznych inne komórki mogą być kontrolowane przez komórki nowotworowe. Oznacza to, że ze szlakami rozwoju nowotworów związana jest cała gama genów i enzymów. Istnieje możliwość celowania w niektóre z nich i blokowania ich ekspresji, co stanowi skuteczną terapię przeciwnowotworową. Wykazano, że metaloproteinazy macierzy (ang. MMP, matrix metalloproteinase) odgrywają kluczową rolę w rozwoju nowotworów złośliwych. Z tego względu w poprzednich badaniach opracowano terapie przeciwnowotworowe oparte właśnie na metaloproteinazach macierzy. Niestety w badaniach klinicznych odnotowano nieprzyjemne reakcje niepożądane. W związku z tym celem europejskiego projektu PROFILING MMP INHIBITI było zdefiniowanie roli metaloproteinaz na poziomie szlaków biochemicznych w celu wyjaśnienia i przewidzenia skutków ich działania. W zależności od struktury metaloproteinazy mogą pełnić całkowicie przeciwne role. Dlatego też na początku badań partnerzy projektu z Uniwersytetu w Liege w Belgii zróżnicowali metaloproteinazy promujące nowotwory oraz metaloproteinazy o działaniu inhibicyjnym, a następnie wykluczyli inhibitory z grupy cząsteczek docelowych. Obiecującym kandydatem był enzym MMP14, który jest czynnikiem angiogenicznym i stymuluje dopływ nowej krwi do komórek nowotworowych. Proteinaza ta działa w połączeniu z dwoma innymi, których silną ekspresję wykazują komórki nowotworowe i które angażują granulocyty obojętnochłonne i miofibroblasty w procesy nowotworowe. Paradoksalnie komórki te zwykle uczestniczą odpowiednio w reakcjach odpornościowych oraz procesach gojenia ran. Cennym wynikiem tych badań jest potwierdzenie, na podstawie uzyskanych danych, wysuniętej poprzednio hipotezy dotyczącej wzajemnych oddziaływań komórkowych. Zespół badawczy zaobserwował, że czynniki wzrostu mogą aktywować metaloproteinazy macierzy na komórkach zrębowych (komórkach tkanki łącznej), a co gorsza jednocześnie indukować produkcję enzymów MMP przez komórki nowotworowe. Informacje uzyskane w tym badaniu rozpowszechniono na dużą skalę poprzez czasopisma naukowe. Badanie to ilustruje stopień zaburzeń funkcji komórek w zależności od ich środowiska biochemicznego. Zidentyfikowano w nim również kluczowe cząsteczki w szlaku prowadzącym od normalnej tkanki do agresywnego nowotworu. Bez wątpienia następnym krokiem jest opracowanie udoskonalonych czynników przeciwnowotworowych.